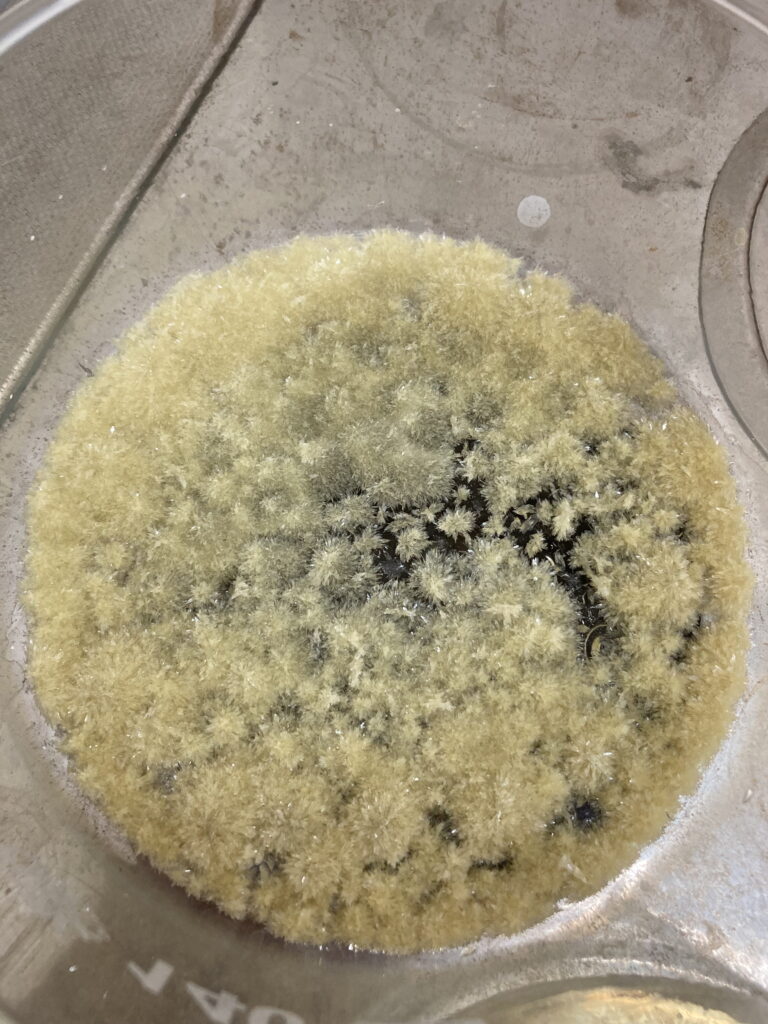

After three months collaborating with TTK (Budapest) and more in concrete Denes Konya research group, some new and reported organic electrolytes have been synthetized. The reported electrolytes serve as a first step being able to compare our Lab-cell design and set up with the reported data in the literature. In this way, InoHub R&D team will be able to determine the most promising KPIs of the new organic electrolytes.
Among the different families reported in the literature for organic aqueous-soluble redox active materials there are two promising families that are the first candidates to be synthetized and tested, the viologens and the quinones. Both anolytes families present important Key Performance Indicators such as suitable redox voltage (-0.7 to -0.4 V vs SHE), high solubility (>1.0 M in water), suitable kinetic constant (>10-3) and diffusion coefficients (> 10-6) well as a high stability (1%/month capacity decay) in the best scenarios.
Quinones
The main difference is that quinones usually need acid or basic media to increase solubility and stability and present two-electrons redox reactions. This last fact is a huge advantage over Vanadium electrolyte which just presents one electron redox reactions. The use of more electrons in the redox reactions will increase the most limitation of RFB the poor energy density. This is an interesting redox active family, and the efforts of R&D team will be focused on find more stable and soluble quinone derivatives.
Viologens
Viologens are a different kind of anolytes, most of them present just one electron redox reaction but in this case the solubility can reach higher values up to 2.0 M. This is another strategy to increase the poor energy density of RFB. Furthermore, these organic electrolytes are stable and soluble at neutral conditions so, the use of corrosive acid as well as fluorinated ion exchange membranes which represent 30% of the costs of the whole battery.
In the future, other redox active families such as TEMPO derivatives, iron complexes, phenazines, alloxazines as well as other alternatives such as the use of solid boosters, mix redox active materials.
ACKNOWLEDGEMENT:
This work was supported by the project: IPCEI_IE_FLOW_BESS_012021